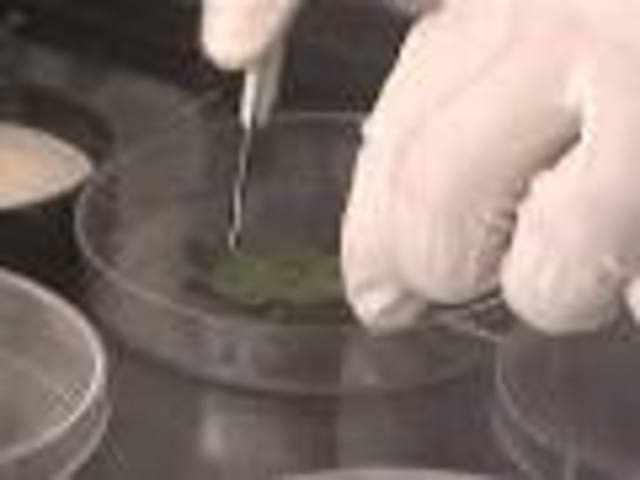
Tissue Cloning

-
-The study of medical science stopped for over 1000 years.
-Medicine practiced only monastaries and convents
-Used herbal medicine
-THere were many plagues and epidemics- Bubonic plague, smallpox, diphtheria, syphilis, tubreculosis. -
-Re-birth of science
-medical schools were built
-the printing press made books possible and knowledge was shared
-Accepted the study of the body by dissection -
at Oxford and Cambridge in England
-
Perfomed many dissections and we got a true idea of wear everything is in the body thanks to Di Vinci's realistic drawings.
-
-
Invented to newly, more visable microscope.
-
William Harvery found that the circulation of blood is caused by the pumping of your heart.
-
invented the vaccination of smallpox
-
In 1784, Ben Franklin created bifocals and latered came to the conclusion that colds were passed from person to person
-
The first stethoscope was created by Rene Leenec.
-
Discoverd many disease-causring organisms- Anthrax, tuberculosis, cholera
-
The first women to qualify as a doctor in the U.S and inspired Florence Nightingale to persue nursing.
-
Created by Florence NIghtingale during the Crimean War.
-
-
Discovered the first x-ray. It allows doctors to see inside the body to discover what was wrong with the patient.
-
Performed with the aid of microscopes, and other specialized instruments, such as a micromaniplator.
-
The first antibiotic.
-
Created by Jonas Salk, going off of Albert Sabin's design.
-
Worlds first heart transplant surgery.
-
-
The first "Test Tube Baby"
First baby made by in vitro fertalization (IVF) -
There was no need to make a really large incision.
-
-
The process of creating an identical copy or an original.
This day was the first day of cloned human embryos.
A list shows items. A timeline shows sequence.
Use Timetoast to make dates, milestones, and turning points easier to understand in a clear visual format. Timetoast is a timeline maker for work, school, research, and stories.